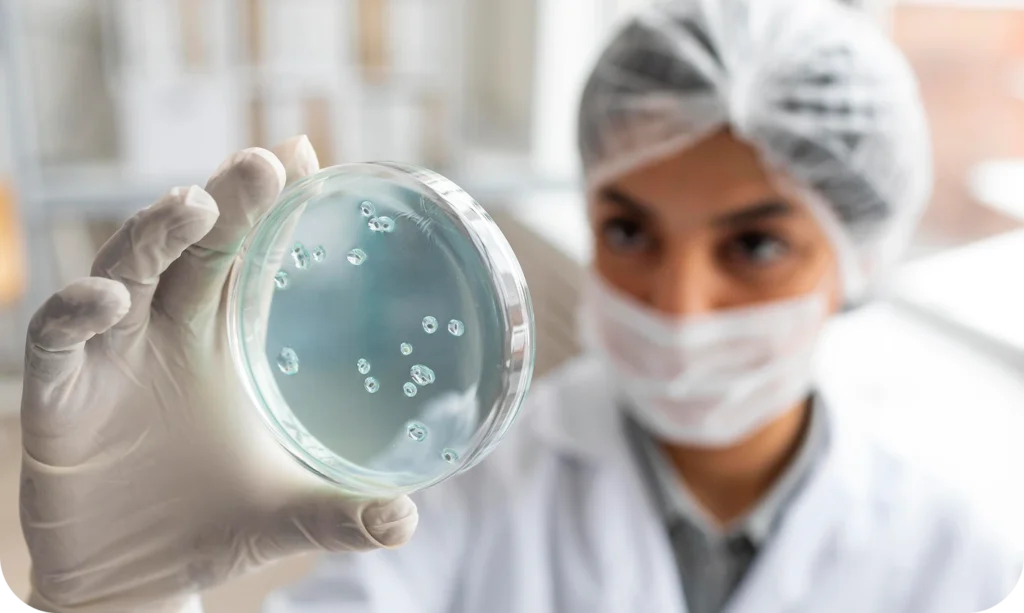

Comprometida com a excelência no cuidado respiratório. Respirar bem é viver melhor.
📍Juazeiro do Norte | Barbalha | Crato
CRM 20657 - RQE 15853
Consulta médica e espirometria
Somente Atendimento Particular

Serviços:

Consulta médica

Exame de Espirometria

Visitas domiciliares

Parecer pneumológico de pacientes internados

Acompanhamento diário de pacientes internados
Somente Atendimento Particular

Sobre Mim
Eu sou a Dra. Bruna Furtado, nascida da cidade de Barbalha, no estado do Ceará e apaixonada pela região do Cariri.
Sou formada em Medicina pela Faculdade de Medicina Estácio de Juazeiro do Norte.
Tenho Residência em Clínica Médica e Pneumologia pelo Hospital Universitário Walter Cantídio/Universidade Federal do Cariri, onde tive a oportunidade de conhecer grandes amigos, profissionais, novas tecnologias, além de aperfeiçoar ainda mais meus conhecimentos e habilidades.
Foram longos 10 anos de muito estudo e dedicação, além das várias atualizações anuais, pensando sempre em VOCÊ, para poder cuidar da sua saúde da melhor forma possível.
Estou aqui para te ouvir, te entender e poder te ajudar da melhor forma possível.
Somente Atendimento Particular
O que trata uma Pneumologista?

Asma

Doença Pulmonar Obstrutiva Crônica

Fibrose Pulmonar

Investigação de Tosse

Investigação de Dispneia

Acompanhamento de Nódulos Pulmonares

Investigação de Derrame Pleural

Avaliação de função pulmonar

Tabagismo

Embolia Pulmonar

Hipertensão Pulmonar

Tuberculose

Pneumonia e outras infecções pulmonares

Bronquiectasias

Pré-Operatório
Investigação de Hemoptise
Somente Atendimento Particular
O que meus pacientes dizem


Alzirene Gomes
Simplesmente maravilhosa, Não foi em vão que me 10 pessoas me indicaram ela, por isso a escolhi para essa nova jornada em minha vida

Nicole
Uma médica excelente, humana e muito preparada e capacitada!

Francielly
Excelente profissional,uma das melhores que já passei

Cj
Uma ótima localização, estalações excelente Foi muito bom o atendimento, na hora marcada, a médica é excelente parabéns pelo bom trabalho.

Josiana Oliveira
Excelente profissional, uma das melhores que já passei
CONTATO
- R. Catulo da Paixão Cearense, 175 - Triângulo, Juazeiro do Norte - CE, 63041-162, Brasil
